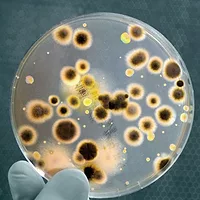
ssPetriDish.jpg

Antibiotic Resistance: An Emerging Food Safety Concern

Antibiotics[1] are drugs capable of killing bacteria or disrupting their reproduction without harming their host, and have been used for more than 70 years to treat people with infections and for more than 50 years in veterinary medicine. They have undoubtedly saved millions of lives, but the establishment of antibiotic-resistant bacteria is jeopardizing their effectiveness. Misuse, overuse and injudicious use of this important class of drugs are being debated by academics, veterinarians, regulators and consumers alike. What all parties can agree upon is that antibiotic resistance is a complicated issue that needs urgent attention and continuing dialogue, as the policies of food production begin to shift to protect these essential drugs from losing their effectiveness.
The need to promote the judicious use of antibiotics in human medicine has long been underway. Many patients are now aware or are being advised by their physicians that antibiotics will not treat viruses, and much public information[2] has been made readily available to thwart the overprescribing of antibiotics. Similar discussions are happening in the veterinary community, which is heralding more veterinary oversight in the treatment of food animals.
Antibiotic resistance emerges through evolutionary pressure. Genetic mutations are expected as bacteria constantly evolve to inhabit their surrounding environments. Reservoirs for many foodborne bacteria are often the gastrointestinal systems of animals. How and what we treat animals with, be it for growth promotion, disease treatment, disease prevention or disease control, can help tip the selection pressures and render chosen antibiotics useless in animal and, ultimately, human medicine.
The emergence of antibiotic-resistant foodborne pathogens is inherently linked to how antibiotics have been used in food animal production. Every time an antibiotic is used, its efficacy diminishes. Once bacteria develop resistance to a given antibiotic, they often lack susceptibility to other antibiotics that share a similar mode of action or coexist on the same bacterial plasmid. Creating policies, both in human medicine and animal husbandry, which will minimize the overuse and misuse of antibiotics is essential.
Antibiotics are given to food animals for many reasons, such as for infectious disease treatment and control, and for disease prevention before a herd- or flock-wide outbreak of disease occurs. During the 1950s, antimicrobial use for growth promotion was widely advocated. The practice enhanced the feed-to-weight ratio for poultry, swine and beef cattle. This buoyed the economic incentive for using subtherapeutic quantities of the antibiotics tetracycline and penicillin in dosages from a tenth to a hundredth of a therapeutic dose, and the use of antibiotics in food animal production for feed efficiency took root.
A Tale of Two Antibiotics
In August 1977, the U.S. Food and Drug Administration (FDA) examined new evidence showing that subtherapeutic use is not safe for humans, and FDA proposed to withdraw approval for all use of penicillin in animal feed. That same year in October, evidence surfaced that subtherapeutic use of tetracycline in animal feed is not safe for humans, and FDA proposed to withdraw its approval as well.
Much of this thinking may have been sparked by a study published in the New England Journal of Medicine by Levy et al. in 1976: “Changes in the intestinal flora of farm personnel after introduction of a tetracycline-supplemented food on a farm.”[3] This study tested isolates from chickens and people on a farm and found low initial levels of tetracycline-resistant intestinal bacteria. As expected under the premise of selective pressure, within 2 weeks after the chickens were fed tetracycline-supplemented feed, 90 percent of the chickens were excreting tetracycline-resistant bacteria. Yet the problem wasn’t isolated to tetracycline; many of the bacteria developed resistance to four antibiotics despite their exposure to tetracycline only. Within 6 months of the administration of tetracycline-spiked feed to chickens, a majority of the people from the farm were excreting antibiotic-resistant bacteria as well. Significantly, when these same persons were tested 6 months after the tetracycline-supplemented feed was discontinued, no detectable tetracycline-resistant organisms were found in the majority of the farm participants. This study showed that the resistant bacteria contained transferable plasmids that conferred multiple antibiotic resistances, not just resistance to tetracycline. The evolutionary pressure imposed by the tetracycline-supplemented feed for multiple drug resistance in chickens extended to humans in contact with the chickens and the feed, but luckily not in statistically significant amounts to their neighbors. (Comparatively, 7 of 11 farm residents compared with only 3 of 24 neighbors, p < 0.01, during the 5- to 6-month feeding period showed fecal samples with greater than 80% tetracycline-resistant coliforms.)
The 1977 Bureau of Veterinary Medicine (today’s equivalent of the Center for Veterinary Medicine—CVM—of FDA) concluded that growth-promotion uses of penicillin and tetracycline (two human medicines) in animal agriculture cause the emergence of resistant strains of bacteria, which can move from agriculture onto the dinner plates of the American public through contaminated food, and thus threaten the health of the general population. For those reasons, they sought, through two Notices of Opportunity for a Hearing (NOOH) published in the Federal Register, to revoke approvals for penicillin and tetracycline.[4] This serves to underline the fact that FDA has consistently believed, for several decades now, that there are human health risks in using subtherapeutic doses of medically important antibiotics in animal agriculture.
Let’s now jump to December 22, 2011, when FDA withdrew the two 1977 NOOHs to reverse its approval to administer penicillin and tetracycline in feed.[5] Instead, FDA stated that they are closing the dockets because they are engaging in other ongoing regulatory strategies developed since the publication of the 1977 NOOHs to address microbial food safety issues.
Although not explicitly stated, this leads one to the conclusion that FDA is turning to the food animal agricultural industry to enforce judicious use itself, and asking that forthcoming voluntary guidance 209 and its companion document 213 be followed.
The FDA states in its recent decision that it “intends to focus its efforts for now on the potential for voluntary reform and the promotion of the judicious use of antimicrobials in the interest of public health. Importantly, this strategy leaves open the possibility of pursuing withdrawal proceedings at a later time if FDA’s proposed strategy does not yield satisfactory results.”[5]
Reading Tea Leaves
So what does the future look like? Based on the timeline provided ( “A Timeline of Antibiotic Regulation,”), anything is possible. What can be ascertained is that using medically important antimicrobial drugs to increase production in food animals is not considered by FDA to be judicious use. Guidance 209 has not been formally issued. However, according to 209, the Draft Guidance “The Judicious Use of Medically Important Antimicrobial Drugs in Food-Producing Animals” gives vast insight into what can be expected.

FDA defines judicious use as “using an antimicrobial drug only when necessary and appropriate.” The effects of medically important antibiotics used as growth promoters in food animals and their effects on increasing antibiotic resistance are clear, and FDA makes some strong statements in the guidance draft to tackle this practice.
“Antimicrobial drugs that are important for treating infectious diseases in people, particularly infections caused by bacteria” are considered the working definition in the draft of medically important antimicrobial drugs. An excerpt from the “Questions and Answers on FDA’s Draft Guidance on the Judicious Use of Medically Important Antimicrobial Drugs in Food-Producing Animals” clears up any misconceptions of FDA’s position on growth promotion:
“Is using medically important antimicrobial drugs to increase production in food-producing animals a judicious use?
No. FDA thinks that using medically important antimicrobial drugs to increase production in food-producing animals is not a judicious use.”
It is therefore reasonable to infer that the FDA is looking to industry to rein in the use of medically important antibiotics for growth promotion/feed efficiency purposes. To evaluate antimicrobial resistance associated with antimicrobial drugs used in food-producing animals, FDA relies on the current approach outlined in the Guidance for Industry (GFI) 152, “Evaluating the Safety of Antimicrobial New Animal Drugs with Regard to Their Microbiological Effect on Bacteria of Human Health Concern.” GFI 152 recommends several measures to reduce the risk of antibiotic resistance.
Risk Analysis—Lack of Resources
Guidance 152 lays out a risk analysis methodology and the recommended process for evaluating antimicrobial drugs for use in food animals as they have the potential to cause antibiotic-resistant illnesses in humans. Considered in the risk-ranking schemes are food consumption and food contamination data, as well as the duration of drug use and its intended administration, be it on individual, select or entire flocks or herds of animals. Out of scope of the guidance are the concerns over residues in food of animal origin.[6] Instead, it focuses on the potential that antimicrobials used in food animals contribute to the emergence of antibiotic strains of foodborne bacteria. “The FDA believes that human exposure through the ingestion of antimicrobial-resistant bacteria from animal-derived foods represents the most significant pathway for human exposure to bacteria that have emerged or been selected as a consequence of antimicrobial drug use in animals.”[7]
Perhaps the most important component of GFI 152 is found in the Appendix, where antimicrobial drugs are ranked Critically Important, Highly Important or Important, according to their significance in human medicine.[7] Antimicrobial drugs that are approved for use in animals are marketed as prescriptions (Rx), over the counter or under veterinary feed directive. FDA asserts that for certain antimicrobial drugs, veterinary supervision is essential in ensuring judicious, and safe, use.
The guidance describes some examples of risk management steps, and how steps might be applied to manage estimated risk levels. Three categories (1, 2 and 3) are given to associate the overall drug risk estimation (high, medium or low). In general, Category 1 includes those drugs ranked “high” in the risk estimation, Category 2 includes those ranked “medium” and Category 3 as “low.”
What GFI 152 has done is pave the way for recent and future FDA actions. As illustrated in the guidance, drugs in Category 1 are subject to the most restrictive use conditions as they are associated with a high-risk ranking. For drugs that are to be marketed as Rx only, extralabel use restrictions would exist, as well as postapproval monitoring by the National Antimicrobial Resistance Monitoring System (NARMS). GFI 152 also outlines that certain Category 2 drugs (medium risk) may be restricted by limiting extralabel use. “Drugs considered to be of high concern (with regard to potential human health impact) would typically be associated with more restricted use conditions.”
Title 21 of the Code of Federal Regulations permits FDA to prohibit the extralabel use of an approved new animal drug or class of drugs in food-producing animals if they determine that “the extralabel use of the drug or class of drugs presents a risk to the public health.”
However, every page of Guidance 152 cautions that it “Contains Non-Binding Recommendations” and further states that “guidances describe the Agency’s current thinking on a topic and should be viewed only as guidance, unless specific regulatory or statutory requirements are cited. The use of the word ‘should’ in Agency guidances means that something is suggested or recommended, but not required.” Given such ambiguities, it is little wonder that advocates for reforms have long been frustrated. FDA has tried for years to rein back what it deems inappropriate usage. Fluoroquinolones aside, the agency’s initiatives seem to fail to gain sufficient support to achieve meaningful regulations. Lack of funding or resources, or pressures external to the agency, may all be stymieing forces.
History in the Making
Recently, a breakthrough and a show of consistent concern came when FDA issued an order prohibiting certain extralabel uses of some cephalosporin antimicrobial drugs in production of major species of food animals. In GFI 152, third-generation cephalosporins are classified as Critically Important, while first- and second-generation are classified as Important along with cephamycins, and all other fourth-generation cephalosporins are deemed Highly Important. Cephalosporins are among the most significant antibiotics in human medicine. Two populations that are most at risk of foodborne illness are children and immune-compromised individuals, and they are also the patients most in need of an effective antibiotic treatment for salmonellosis with minimal side effects. Indeed, ceftriaxone or cefotaxime, third-generation cephalosporins, are often the treatment of choice for severely complicated pediatric salmonellosis because unlike other antibiotics, such as fluoroquinolones and tetracyclines, there are no warnings for use in children. Cephalosporins are part of the broader group of antibiotics known as b-lactams. Other b-lactams include penicillins as well as tetracyclines, and all work to destroy bacteria in a similar fashion. The World Health Organization considers both penicillins and tetracyclines to be Critically Important in human medicine, unlike the FDA, which considers them only Highly Important. Another drug class, fluoroquinolones, considered Critically Important by FDA, was successfully banned for extralabel use in food animals and any use was banned in poultry over concerns of antibiotic resistance.
Antibiotic resistance impacts public health when people consume food contaminated with antimicrobial-resistant bacteria resulting from the exposure of food animals to antimicrobials, including cephalosporins. Gram-negative bacteria acquire or have innate resistance to cephalosporin through b-lactamases, which inactivate the drug itself.[8] CMY-2, a type of AmpC enzyme, and the extended-spectrum b-lactamases (ESBLs) are found on the chromosomes of most Enterobacteriaceae and on plasmids in Salmonella, Escherichia coli and other Enterobacteriaceae. CMY-2 and ESBLs provide resistance to first-, second- and third-generation cephalosporins. CMY-2 is the b-lactamase most associated with Salmonella from isolates that display resistance to ceftiofur and increasing resistance to ceftriaxone.[9–11] ESBLs present in bacteria of human concern include CTX-M, which is plasmid-mediated and has the potential to provide resistance to all cephalosporins. Although now dominant only in European countries, CTX-M enzymes are gaining a foothold in the United States but do not yet predominate.[12, 13] When mobilized, CTX-M enzymes often can be found on large multidrug-resistant plasmids. FDA is concerned that cephalosporin resistance may escalate as CTX-M becomes more widespread. Severe bacterial infections resistant to cephalosporins, without FDA’s continued action, may face treatment failures from ineffective antibacterial regimens, increasing the likelihood of death.
Of particular concern is the evidence of cross-resistance among drugs in the broad cephalosporin class and the increase in reports of CMY-2 and CTX-M b-lactamases, which transfer cephalosporin resistance between enteric bacteria.[9] The surveillance efforts of both the NARMS as well as the Canadian Integrated Program for Antimicrobial Resistance Surveillance have noted both in animal and human isolates the acquired resistance to b-lactams. Resistance to ceftiofur corresponds with resistance to ceftriaxone, conferred by CMY-2, and provides resistance to first-, second- and third-generation cephalosporins. Resistance to ceftiofur compromises the efficacy of ceftriaxone, a first-line therapy for treating human salmonellosis. CMY-2, in addition to providing ceftiofur and ceftriaxone resistance, conveys resistance to many other b-lactams, including ampicillin and amoxicillin.[14] The concern over the pervasiveness and range of CMY-2 in the ceftiofur and ceftriaxone surveillance data helps provide the basis for FDA’s action as it supports the findings that cephalosporin use in food animals is contributing to an upsurge in cephalosporin-resistant pathogens.[15]
The recent issuance is not an all-out prohibition of cephalosporin use in food animals. Many have complained that it is watered down compared with what was put forth in 2008, while some former critics now indicate that it is more reasonable.
Prohibition in the 21st Century
As stated in the prohibition issuance, and in many agency documents in regard to the use of antimicrobial drugs in animals, “When considering the foodborne pathway, the potential for human exposure to antimicrobial-resistant pathogens is significantly less for food derived from minor species than it is for food derived from the food-producing major species. The exposure potential is less in part because the amount of food derived from cattle, swine and poultry is much greater than the amount of food derived from sheep, goats and aquaculture, the minor species from which the most food is derived.” Minor species are defined as animals other than cattle, swine, chickens, turkeys, horses, dogs, cats and humans. At this time, FDA is not planning to prohibit extralabel use of cephalosporins in food-producing minor species because they do not believe that this use represents a significant risk to the public health, since these species are consumed less frequently.[16] Also, because cephalosporins are approved for use in sheep and goats, there is less potential for extralabel use in these species, according to the agency. Although people may consume these animal species less often, any practice that selects for resistance genes is concerning.
The ban is slated to officially take effect on April 5, 2012. Under Title 21 of the Code of Federal Regulations, parts 530.21 and 530.25, the FDA order of prohibition applies to certain extralabel uses of the cephalosporin class of antibiotics in food animals. This is a result of findings that such uses are likely to cause an adverse event. The order of prohibition states that excluding cephapirin, cephalosporins are prohibited from extralabel use in cattle, swine, chickens and turkeys for disease prevention purposes. Cephapirin is one of two cephalosporin drugs approved for use in food animals. Prohibition in the major species of food animals prevents using cephalosporins at unapproved doses. The ban prohibits using cephalosporins at unapproved frequencies and durations, and for unapproved routes of administration. Also prohibited is use of cephalosporins when the drug is not approved for a particular species and production class. Said another way, since ceftiofur is the only other cephalosporin drug approved for use in food animals, extralabel use of ceftiofur is permitted in food-producing major species to treat or control an extralabel disease indication, but only when it is approved for and labeled for use in that particular species and production class. Prophylactic use of ceftiofur is therefore not permitted in major species of food animals. Additionally, ceftiofur is to be administered only at dose levels, frequencies, durations and routes of administration that are clearly stated on approved labeling for that particular species and production class. Other cephalosporin drugs, apart from ceftiofur and cephapirin, are prohibited for all uses in the major species of food animals.
It is hoped that the ban will have a positive public health impact and help end the use of cephalosporins that are proven to cause resistant infections in people.
In the Midst of Outbreaks
The warnings and calls for action have been coming for years. From the Swann Report issued in 1969 to the more recent media coverage and public meetings, food safety concerns over antibiotic resistance are increasing. We are beyond the hypothetical “if” people contract antibiotic-resistant foodborne infections. As recent outbreaks prove, we are in a crisis.
Outbreaks of antibiotic-resistant infections occurring from food products in 2011 brought the concern again to the forefront of consumers’, and food companies’, awareness as regulators modified their recall notices to alert the public to the dangers of antibiotic resistance in meat and poultry products.
Notable recalls of 2011 include the following:
• December’s “Northeastern Grocery Chain Recalls Ground Beef Products Due to Possible Salmonella Contamination,” in which we learn that the outbreak strain of Salmonella Typhimurium initially tested resistant to multiple commonly prescribed antibiotics, including drug classes such as b-lactams, aminoglycosides and cephalosporins. The U.S. Department of Agriculture (USDA) Food Safety and Inspection Service (FSIS) along with Centers for Disease Control and Prevention (CDC) also noted that the strain’s resistance can “increase the risk of hospitalization or possible treatment failure in infected individuals.”[17]
• September’s “Arkansas Firm Recalls Ground Turkey Products Due to Possible Salmonella Contamination,” which noted in an update on the 27th that the sample of ground turkey referenced in the September 11 recall was confirmed as the Salmonella Heidelberg outbreak strain (XbaI PFGE pattern 58/BlnI pattern 76) and FSIS had lab results that indicated the isolate is resistant to ampicillin, gentamicin, streptomycin and tetracycline. FSIS noted that “this antibiotic resistance may be associated with an increased risk of hospitalization or possible treatment failure in infected individuals.”[18]
• The August 3 recall “Arkansas Firm Recalls Ground Turkey Products Due to Possible Salmonella Contamination,” which stated that 36 million pounds of ground turkey products may have been contaminated with a multidrug-resistant strain of Salmonella Heidelberg and followed a July 29 FSIS Public Health Alert initiated due to concerns about illnesses caused by Salmonella Heidelberg.
• The April 2011 recall “Minnesota Firm Recalls Turkey Burger Products Due to Possible Salmonella Contamination.” Implicated in this recall was Salmonella serotype Hadar. Although not noted in the FSIS recall, CDC in its outbreak reporting noted, “The outbreak strain of Salmonella Hadar is resistant to many commonly prescribed antibiotics, which can increase the risk of hospitalization or possible treatment failure in infected individuals.” Salmonella Hadar was resistant to at least ampicillin, amoxicillin/clavulanate, cephalothin and tetracycline. This recall sparked much consumer concern because of the labeling “All Natural.” The vast majority of the consuming public doesn’t recognize that the definition of “natural” would exempt antibiotics.[19] Therefore going against most consumers’ logic, the routine use of antibiotics is a “natural” way to raise food animals.
The time to address the problem of antibiotic-resistant foodborne infections is long overdue. How many more cases are needed before the federal government imposes stricter regulations?
The U.S. government can take immediate steps to help further protect the public health. Draft Guidance for Industry 209 should be finalized and issued by FDA to protect against the inappropriate use of antibiotics as growth promoters or for feed efficiency in food animals; not doing so in a timely manner gives the impression to consumers that the Obama administration is not interested in addressing this public health emergency.
How many more hospitalizations from antibiotic-resistant foodborne infections does it take before large numbers of industry leaders proactively work to protect their brands and the consumers who trust in the safety of their purchase?
Brand Protection and Practices: A Way Forward
Consumers are showing more interest in the source of their food and, in the case of food animals, how they are raised. The food industry is now, more than ever, recognizing that “food safety” means more than just microbiological control—it also incorporates consumer perceptions of what is considered safe.
Rather than enduring lawsuits and the pitiless media, meat and poultry industry leaders can proactively adopt practices and publicly declare their intentions to reduce use of medically important antibiotics. Industry leaders who take responsibility and pride in their products should declare their policies and make consumers aware of the practices they employ. Corporations should publish on their websites and in printed materials their policies on antibiotic usage, state support for judicious use and highlight that antibiotics are not being used for growth promotion. Knowing that the most important antibiotics should be preserved for human medicine, industry leaders may want to voluntarily restrict use of classes of antibiotics—tetracycline, penicillin, macrolide, lincosamide, streptogramin, aminoglycoside and sulfonamide—except for the treatment of sick or diseased animals.
The outlined principles come from legislation introduced by Congress’s only microbiologist, Representative Louise Slaughter of New York. The Preservation of Antibiotics for Medical Treatment Act (PAMTA) has historically received bipartisan support, yet has not been able to gain enough traction to make its way through a divided Congress.
A novel idea would be for industry leaders, many of whom read this publication and who are concerned about the injudicious use of antibiotics, to adopt the principles of PAMTA well in advance of any forthcoming government regulations. This enlightened self-interest may improve their market base, public perception and ultimately their product.
Susan Vaughn Grooters, M.P.H., serves as director of research and education at STOP Foodborne Illness (formerly S.T.O.P. Safe Tables Our Priority) and is an executive committee member for the coalition Keep Antibiotics Working (KAW). She holds a B.S. in food sciences and nutrition from the University of Vermont and an M.P.H. in epidemiology from the University of Massachusetts–Amherst. An inducted member of Delta Omega, the National Honorary Society for Public Health, Grooters was also recently appointed by USDA Secretary Tom Vilsack as the consumer representative for the National Advisory Committee on Microbiological Criteria for Foods.
References and Notes
1. “Antibiotic” is the commonly used term to describe antibacterial drugs and will be used as such in this article. However, the author would like to acknowledge the more strict definition of “antibiotic” as being a compound that is naturally produced or derived from a fungus or other microorganism that has the ability to inhibit bacterial reproduction that causes illnesses in humans and animals. However, some antibacterial drugs may be synthetically produced and derived compounds (e.g., not “naturally” occurring, or produced by a fungus, etc.) and therefore would not meet the strict definition of the term “antibiotic.”
2. www.cdc.gov/getsmart.
3. Levy S.B., G.B. FitzGerald and A.B. Macone. 1976. Changes in intestinal flora of farm personnel after introduction of a tetracycline-supplemented feed on a farm. N Engl J Med 295(11): 583–588.
4. Notice of Opportunity for a Hearing (NOOH) that the agency published in the Federal Register on Tuesday, August 30, 1977, for penicillin and a companion NOOH revoking approval for tetracycline (published in the Federal Register Friday, October 21, 1977).
5. Federal Register Volume 76, Number 246 (Thursday, December 22, 2011), 79697–79701.
6. Residue vs. resistance. This article purposefully did not address drug residues that may be present in foods of animal origin. The residue violator list, kept by the USDA, records both producers and violations. This helps not only to keep a public record, but also to prevent actual drugs showing up in the food that the public consumes. Although this might elicit the “yuck” factor, withdrawal times and other practices that are in place help mitigate the risk that someone would actually “eat” antibiotics in any given meal.
7. www.fda.gov/downloads/AnimalVeterinary/GuidanceComplianceEnforcement/ GuidanceforIndustry/ucm052519.pdf.
8. Livermore, D.M. 1995. Beta-lactamases in laboratory and clinical resistance. Clin Microbiol Rev 8:557–584.
9. Li, X.Z. et al. 2007. b-lactam resistance and b-lactamases in bacteria of animal origin
Looking for quick answers on food safety topics?
Try Ask FSM, our new smart AI search tool.
Ask FSM →